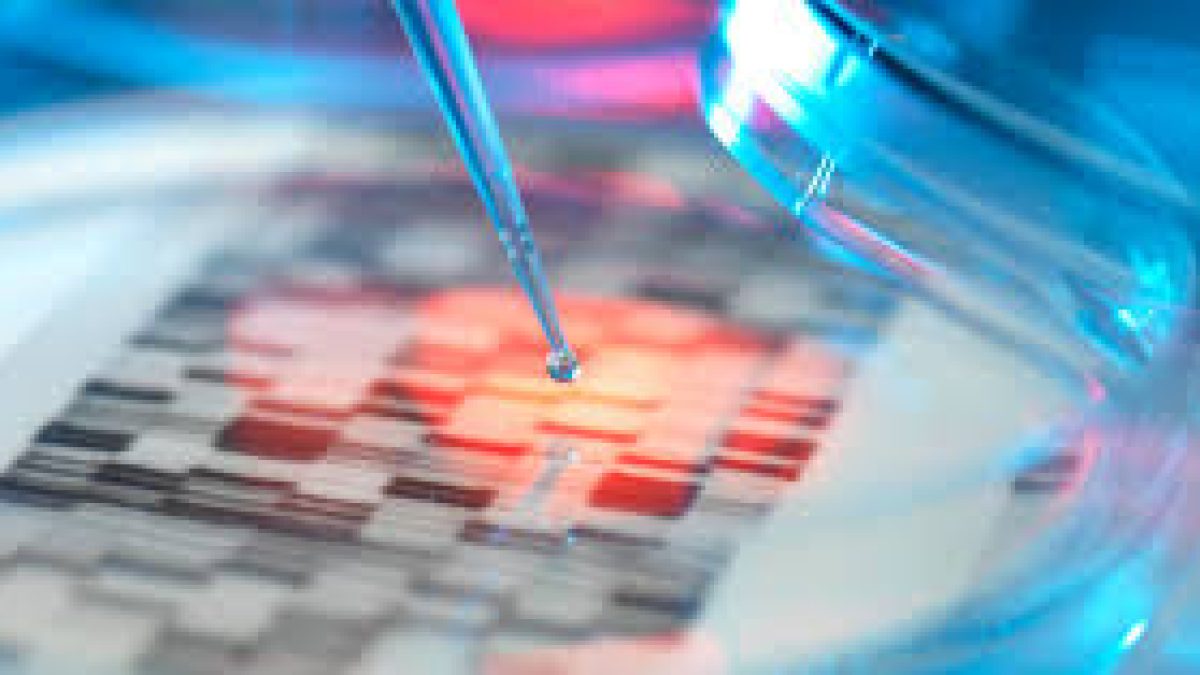
DST develops antiviral nano-coatings for making triple layer medical masks and N-95 respirator

Department of Science and Technology (DST), Ministry of Science and Technology has approved support for upscaling antiviral nano-coatings as part of Nano Mission program. The antiviral nano-coating was developed by Professor Ashwini Kumar Agrawal of the Indian Institute of Technology, Delhi.
Antiviral nano-coatings:
♦ Antiviral nano-coatings will be used as an appropriate material for producing anti-COVID-19 Triple Layer Medical masks and N-95 respirators in large quantities.
♦ Under the nano mission project, N9 blue nanosilver was developed at SMITA Research Lab, IIT Delhi. Silver has a strong antimicrobial activity against bacteria, viruses, fungus, and so on.
♦ The N9 blue nanosilver is a highly potent antimicrobial agent. It will be further modified to form nanocomplexes with Zinc compounds to achieve a synergistic effect.
♦ Also, these newly developed nanomaterials will be applied as coatings on facemasks and other Personal protective equipment (PPEs) to improve their ability to protect the wearer from accidental contamination from COVID-19 virus droplets.
♦ The upscaling work of the project will be held in association with 2 industrial partners Resil Chemicals Pvt Ltd. Bangalore and Nanoclean Global Pvt Ltd., New Delhi.
♦ Resil chemicals will provide N9 blue nanosilver. Nanoclean Global will provide face masks and PPE materials for the application of nanocoating and will help in the design and fabrication of samples at their facilities.
♦ The use of highly effective antimicrobial nanoparticles on PPEs, masks, etc is the need of the hour.
♦ The Antiviral nano-coatings will provide an extra layer of protection for the high-risk settings, such as for the medical workers.
♦ The antiviral properties of this compound against COVID-19 in association with AIIMS, New Delhi, and ILBS, New Delhi will be evaluated. The shelf life of the coatings will be evaluated and their efficacy with different storage conditions such as temperature, humidity, and time and prepare facemasks and PPEs and provide these for field trials.